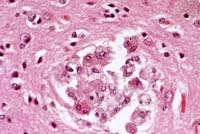

Results
AFIP Wednesday Slide Conference - No. 14
14 January 1998
Conference Moderator: Dr. Philip J. Snoy, Diplomate,
ACVP
FDA/CBER/DVS
HFM-270
8800 Rockville Pike, Bldg. 29A
Bethesda, MD 20892
Return to WSC Case Menu.
Case I - 79067 (AFIP 2598252)
Signalment: Juvenile, male, pig-tailed macaque (Macaca
nemestrina).
History: This monkey was found dead in his cage on July
15, 1996. He had been treated for dental infection and possible
secondary infection, had not been eating well, and had transient
diarrhea. He was currently on an SIV/HIV chimeric virus (SHIV)
study. He had been inoculated with virus on December 1, 1995.
This monkey had been monitored for possible secondary pneumonia
as a result of a broken tooth (incisor) as the possible source
of infection. Chest x-rays showed no indications of pneumonia.
The broken tooth was extracted on January 18, 1996. He was started
on antibiotics and analgesics/non-steroidal anti-inflammatory
drugs. He was given soft biscuits, fruit and supplemental fluids.
The monkey was depressed, but was still mobile in the cage and
became vocal when approached.
Gross Pathology: The monkey was mildly autolytic and dehydrated
and had scant body fat stores. The stomach contained fruit pulp
and monkey chow. There was normal ingesta in the small intestine
and cecum, and semi-formed feces in the colon. The urinary bladder
contained a small amount of clear, yellow urine. The thymus was
diffusely atrophied. The cranial and intermediate lung lobes were
firm and consolidated. There was a tan exudate in the bronchi.
Samples were taken for bacteriology and cytology. The distal trachea
and mainstem bronchi contained a small amount of bloody exudate.
A center incisor tooth was missing. There was no evidence of inflammation
in the adjacent gingiva. Other organ systems were grossly unremarkable.
Laboratory Results: Urinalysis (Multistixâ dipstick):
ketones = +1, SG = 1.020, pH = 6; other values normal.
Contributor's Diagnoses and Comments:
- 1. Kidney: Tubular degeneration and necrosis, multifocal,
moderate, with multifocal, mild, interstitial, subacute nephritis
and numerous, basophilic, intranuclear inclusions.
- 2. Lung: Pneumonia, interstitial, fibrinous, subacute, diffuse,
severe, with type II pneumocyte hyperplasia and intraepithelial,
basophilic intranuclear inclusions.
Other tissues examined:
Spleen, lymph nodes: lymphoid depletion, diffuse, moderate.
Thymus: lymphoid depletion, diffuse, severe.
Small intestine: Amyloid, villi, multifocal, mild.
Liver: Hemosiderosis, Kupffer cells, multifocal, mild.
Final Diagnosis Remarks: Pneumonia and dehydration were
likely the major contributing factors to this animal's death.
The renal lesion was characterized by tubular degeneration associated
with hypertrophied cells containing smudgy intranuclear inclusion
bodies. In the lung, there were extensive areas of interstitial
and exudative pneumonia, with prominent type II pneumocyte hyperplasia
and indistinct intranuclear inclusion bodies. These changes are
most likely the result of infection with SV40 virus, but cytomegalovirus
infection must be included as a differential. SV40 is a papovavirus
which is generally latent in Asian macaques. Reactivation and
clinical disease have been documented in immunocompromised animals,
including those infected with SIV. SV40 can also cause encephalitis;
there was no evidence of brain infection in this case. The hepatic
hemosiderosis likely resulted from blood transfusions.
There are several synonyms for Simian Virus 40 infection including
vacuolation agent infection, progressive multifocal leukoencephalopathy
and papovaviral tubulointerstitial nephritis.
Gross lesions are subtle and have only been described in the
brain, lungs, and kidneys. In the brain, multiple 1-3 mm, soft,
gray-pink to translucent foci may occur in subcortical white matter,
hypothalamus, medulla oblongata and adjacent to the cerebral aqueduct.
SV40 induced interstitial pneumonia may be characterized by firm,
red, patchy areas in the lungs, which do not collapse when compressed.
Histologically, brain lesions consist of multifocal to coalescing
areas of demyelination throughout the cerebral white matter and
subependymal regions. These areas are often associated with foci
of microgliosis and glial nodules may be evident in overlying
gray matter. Intranuclear inclusion bodies in oligodendro-gliocytes
and astrocytes may be present in early lesions. Early forms of
inclusions are lightly basophilic and granular and later forms
are condensed and more intensely basophilic.
Lung lesions consist of patchy areas of interstitial pneumonia
characterized by variable septal thickening due to congestion
or histiocytic or fibroblast infiltration. Affected alveoli are
lined by hyperplastic and hypertrophied type II pneumocytes, some
of which contain intranuclear inclusion bodies.
Scattered collecting tubules in the inner cortex and medulla
of the kidney are lined by hypertrophied epithelial cells containing
intranuclear inclusion bodies. These necrotic lining cells desquamate
into the tubular lumina and form cellular casts.
Differential diagnosis must include other viruses infecting
macaques which cause intranuclear inclusion bodies. Agents to
consider include adenovirus, cytomegalovirus, Herpesvirus simiae
and other herpesviruses.
Natural History and Epidemiology: Simian virus 40 is
a common latent infection of feral and captive Asian monkeys,
especially Macaca mulatta, M. fuscata, M. cyclopis, and to a lesser
extent M. fascicularis. However, SV40 rarely causes clinical illness
in these species.
SV40 was originally isolated from normal appearing rhesus and
cynomolgus kidney cell cultures and from seed stocks of poliovirus
and several strains of adenovirus grown in these cell cultures
for human vaccine production. Although SV40 replicates to high
titer in kidney cell cultures, the cells show no cytopathic effect.
However, when SV40-infected cell culture medium is used to inoculate
cultures of African green monkey kidney cells, these cells develop
prominent cytoplasmic vacuolization. This observation led to the
original designation of SV40 as "vacuolating agent"
or "vacuolating virus". SV40 is not a significant cause
of clinical illness in macaques, with the only reported cases
of active SV40 infection involving monkeys with suspected or confirmed
immune dysfunction. In at least two reports, the cause of the
immune compromise resulting in reactivation of latent SV40 infection
in these monkeys has been confirmed as simian immunodeficiency
virus (SIV) infection.
Etiology: Simian virus 40 is a 45 nm, unenveloped, icosahedral,
DNA-containing virus in the subfamily Polyomavirinae, family Papovaviridae.
The virus genome contains early and late coding regions and a
non-coding regulatory region. The early region encodes for two
DNA binding proteins, referred to as large and small T (tumor)
antigens. T antigens bind to the viral regulatory sequences to
facilitate transcription of the late viral genes. The late genes
encode for three capsid proteins which contain genus-specific
antigens. The virus transforms a variety of rodent cells in vitro
and is oncogenic in several rodent species in vivo.
Pathogenesis: Natural transmission of SV40 infection
in macaques is thought to occur via the respiratory route. Rhesus
and African green monkeys have been experimentally infected via
intranasal, intragastric and subcutaneous routes. Experimental
inoculation did not cause clinical illness, but a number of animals
developed azotemia and red blood cell casts in their urine, indicating
mild, transient impairment of renal function. SV40 is excreted
in high concentrations in the urine and infected urine may serve
as the principal source of infections of susceptible animals.
During the first week of infection, animals become viremic. Neutralizing
antibodies occur in the blood 21 days post-infection and in the
urine by 9 weeks post-infection. The virus then enters a latent
state, persisting in renal epithelium indefinitely. Latent infections
may reactivate if the host immune response is impaired, with the
possible development of lesions in the brain, lungs and kidneys.
- Comparison with other species: SV40 induces a wide
variety of tumors when inoculated into hamsters. The type of
tumor induced varies depending on the dose and route of inoculation
of the virus. Tumors have also been experimentally induced in
mice when inoculated with the virus.
A high percentage of people harbor one or two papovaviruses related
to SV40 which have been associated with clinical disease in immune
compromised patients. These agents, referred to as JC and BK
viruses, are acquired during childhood, presumably as a mild,
subclinical respiratory infection. Following this primary infection,
the viruses become latent in the kidneys. In immune compromised
patients, JC virus may become reactivated and cause the demyelinating
disease, progressive multifocal leukoencephalopathy. Reactivated
latent BK virus infection has been associated with kidney infection
in renal transplant patients and with cystitis in patients receiving
bone marrow transplants. In addition, BK virus genomic sequences
have been associated with pancreatic islet cell tumors, various
brain tumors and Kaposi's sarcoma, but its role in induction
of these tumors has not been established.
-

- Case 14-1a. Lung. Mixed leukocytes and fibrin expand
the interstitium with serofibrinous exudate and alveoli contain
sloughing type II pneumocytes with diffuse basophilic nuclear
inclusions. 40X

- Case 14-1b. Kidney. Cortical tubule epithelium is
necrotic and often contains basophilic nuclear inclusions. 40X
- AFIP Diagnoses:
- 1. Lung: Pneumonia, interstitial, subacute, diffuse, moderate,
with type II pneumocyte hyperplasia and intranuclear amphophilic
to basophilic inclusion bodies, pig-tailed macaque (Macaca nemestrina),
primate.
2. Kidney, tubules: Degeneration, necrosis, and regeneration,
multifocal, with cellular casts and intranuclear amphophilic
to basophilic inclusion bodies.
3. Kidney: Nephritis, interstitial, chronic, multifocal, minimal.
Conference Note: Several conference participants considered
Pneumocystis carinii in the differential diagnosis of the pulmonary
lesion; however, no special stains were available.
Contributor: FDA/CBER/DVS, HFM-270, Bldg. 29A, Rm. 1A-17,
1401 Rockville Pike, Rockville, MD 20852-1448
References:
- 1. King NW: Simian virus 40 infection. In: Nonhuman Primates
I, Jones TC, Mohr U, Hunt RD (eds.), pp. 37-42, Springer-Verlag,
1993.
- 2. Horvath CJ, Simon MA, Bergsagel DJ, Pauley DR, King NW,
Garcea RL, Ringler DJ: Simian virus 40-induced disease in rhesus
monkeys with simian acquired immunodeficiency syndrome. Am J
Path 140(6):1431-1439, 1992.
- 3. Sheffield WD, Strandberg JD, Braun L, Shah E, Kalter SS:
Simian virus 40-associated fatal interstitial pneumonia and renal
tubular necrosis in a rhesus monkey. Journ of Infect Dis 142(4):618-621,
1980.
Case II - CP-96-321 (AFIP 2595775)
Signalment: 2.5-week-old, C57BL/6, male mouse.
History: This mouse was one of an entire litter reported
with alopecia over the back and axillary region. This litter was
housed in a colony with a history of MHV (mouse hepatitis virus)
and EDIM (epizootic diarrhea of infant mice).
Gross Pathology: Other than alopecia over the dorsal
back and axillary region, no gross lesions were found.
Laboratory Results: ELISA and IFA serology tests were negative
for MHV and positive for EDIM. Fur plucks were negative for mites
and negative for fungal pathogens.
Contributor's Diagnoses and Comments:
- 1. Diffuse, superficial ballooning degeneration of small
intestinal epithelium.
- 2. Multifocal, mild, acute perifollicular dermatitis [tissue
not submitted for conference].
Etiology: Murine Rotavirus
Murine rotavirus is an RNA virus in the family Reoviridae.
This virus replicates in the epithelial cells of the small intestine
and causes the diarrheal disease EDIM (epizootic diarrhea of infant
mice). All ages of mice are susceptible to infection, but clinical
disease is seen only in mice 7 to 14 days of age. Disease is characterized
by mucoid yellow diarrhea. Affected animals may be stunted but
continue to nurse. This disease is associated with high morbidity
but low mortality. Microscopically, lesions are restricted to
the tips of the small intestinal villi and consist of vacuolization
and swelling of epithelial cells. Inflammation is minimal or absent.
Vascular congestion and lymphatic dilation may also be present.
The virus is spread by the fecal-oral route and there is no evidence
of transplacental infection.
- Other causes of diarrhea in infant mice include enteric mouse
hepatitis virus (MHV), reovirus type 3, Salmonella sp., and Spironucleus
muris. This litter was from a colony that had a prior history
of MHV and EDIM. In this case, the lack of clinical signs, the
restriction of microscopic lesions to the villous tips, and the
lack of syncytial cells are findings which are more consistent
with EDIM than MHV. The rest of the litter remained asymptomatic.
The cause of the hair loss was not determined, but on weaning
the haircoat returned to normal. This may indicate the cause
of hair loss was excessive grooming by the mother with resultant
mild secondary inflammation.
-

- Case 14-2. Intestine. Diffuse vacuolar degeneration
of the villus tip enterocytes. 20X
- AFIP Diagnosis: Small intestine, villar tips, enterocytes:
Vacuolar degeneration, diffuse, moderate, C57BL/6 mouse, murine,
etiology consistent with murine rotavirus.
Conference Note: Susceptibility to rotaviral infection
is primarily related to mucosal epithelial turnover kinetics,
not the host's immune status. Therefore, adult SCID mice, like
immunocompetent mice, do not develop lesions or clinical disease
when infected with rotavirus. In neonatal mice, however, both
passively and actively acquired immunity are thought to be important
in host defense mechanisms. Neonatal athymic (nu/nu) mice experimentally
infected with murine rotavirus experience a self-limiting infection
identical to that seen in age-matched immunocompetent mice. In
contrast, neonatal SCID mice have a higher percentage of enterocytes
infected, achieve greater concentrations of virus in intestinal
epithelium, shed higher concentrations of virus for longer periods
of time in the feces, and remain persistently infected.1
Contributor: Division of Comparative Medicine, University
of Texas, Southwestern Medical Center at Dallas, 5323 Harry Hines
Blvd., Dallas, TX 75235-9072
References:
- 1. Committee on Infectious Diseases of Mice and Rats, Institute
of Laboratory Animal Resources. Infectious Diseases of Mice and
Rats, pp. 111-116, National Academy Press, Washington, D.C.,
1991.
- 2. Foster HL, Small JD, Fox JG, eds.: The Mouse in Biomedical
Research, vol. 2, pp. 160-167, Academic Press, New York, 1982.
- 3. Fox JG, Bennet JC, Loew FM, eds.: Laboratory Animal Medicine,
pp. 67-68, Academic Press, New York, 1984.
- 4. Jones TC, Mohr U, Hunt RD, eds.: Digestive System. Monographs
on Pathology of Laboratory Animals, pp. 321-325, Springer-Verlag,
New York, 1985.
- 5. Waggie K, Kagiyama N, Allen AM, Nomura T: Manual of Microbiologic
Monitoring of Laboratory Animals, 2nd ed., pp. 101-106, National
Institutes of Health, NIH publication No. 94-2498, 1994.
International Veterinary Pathology Slide Bank:
Laser disc frame #10149, 13527, 16052, 16267-9.
Case III - 79066 (AFIP 2598235)
Signalment: Adult, male, rhesus monkey.
History: This monkey was experimentally infected with
SIV on July 1, 1995. He was on a protocol for treatment with human
chorionic gonadotropin (HCG) to monitor the effect of HCG on the
immune system. This animal began showing signs of neurological
involvement approximately 10 days prior to death.
Gross Pathology: The animal was moderately dehydrated
with scant body fat stores. A sample of clear, straw-colored cerebrospinal
fluid was taken from the cisterna magna for bacterial culture
and cytology. All lymph nodes were enlarged 5-15 times normal
size. The spleen was 1.5 times normal size with prominent lymphoid
follicles. There were multiple, elongate yellow plaques on the
esophageal mucosa and a sample was taken for fungal culture. There
were similar plaques on the mucosa of the body of the stomach,
2-4 mm in diameter. The stomach was empty. There was a small amount
of fluid in the small intestine, and a small amount of normal
ingesta in the cecum. The colon was distended by yellow fluid
contents. Other organ systems were grossly unremarkable.
Contributor's Diagnosis and Comments:
Brain, cerebrum: Meningoencephalitis, histiocytic and lymphocytic,
multifocal, mild with diffuse, moderate white matter spongiosis.
Occasional cytomegalic cells were found associated with the
marked suppurative neuritis affecting the spinal nerves; presumably
this lesion is the result of cytomegalovirus infection. In the
optic nerves there was mild to severe perivascular necrosis, with
infiltration of macrophages and neutrophils, reactive neurolemmocytes,
and rare multinucleated syncytial cells. The perivascular infiltration
of macrophages and few lymphocytes found in the brain is a characteristic
lesion of SIV in macaques. Rare syncytial cells were seen. The
vacuolar change throughout the white tracts of the brain is likely
due to axonal degeneration, possibly secondary to the cord lesions.
There was spinal myelitis similar to, but more necrotizing than,
the lesion in the brain. It consisted of parenchymal necrosis
and axonal degeneration, with infiltrates of large foamy macrophages
and neutrophils. Careful scrutiny and special stains failed to
demonstrate an etiologic agent. The lesions in the brain, optic
nerves and spinal cord are presumed to reflect direct cytopathic
effects of SIV. A pneumonia was seen consistent with that attributed
to SIV; again special stains failed to demonstrate etiologic agents.
Lymph node hypertophy and necrosis was striking; this again was
apparently due to direct SIV effects. In the liver, the lymphoid
infiltrates included large blastic cells and cells containing
mitotic figures. This and lymphoid infiltrates in other organs
may represent SIV-induced lymphoid proliferation. A vasculopathy
noted in several organs may be due to direct effects of SIV on
endothelial cells. Esophageal and gastric candidiasis was seen,
likely the result of SIV-induced immunosuppression. The colitis
is likely also due to SIV infection.
Microscopic Findings: Approximately 50% of rhesus monkeys
experimentally infected with SIVMAC develop a characteristic meningoencephalitis
which resembles the encephalopathy which occurs in a high percentage
of human patients with acquired immunodeficiency syndrome. For
unknown reasons, this lesion has not been observed in rhesus with
colony-acquired SIV infection. Lesions are seen in the gray and
white matter of the brain and spinal cord, but white matter is
most commonly affected. The meninges and choroid plexuses are
less commonly affected. The lesions are characterized by multifocal
perivascular infiltrates of finely vacuolated macrophages and
multinucleate giant cells throughout the cerebrum, cerebellum,
brain stem and spinal cord. Occasional lesions may contain low
numbers of neutrophils or lymphocytes. Mild myelin loss may be
observed around these lesions. There may be scattered glial nodules
throughout affected brains. The leptomeninges and choroid plexus
may be infiltrated by histiocytes, giant cells and varying numbers
of fibroblasts. SIV viral particles are present within cytoplasmic
vacuoles of the histiocytes and giant cells. SIV RNA has been
identified by in situ hybridization in histiocytes and giant cells
and rarely in glial cells.
Natural History: Naturally occurring infections in native
nonhuman primate populations have been reported only in African
species in which they exist commonly as persistent infections
unassociated with clinical disease. Although several Asian species
of the genus Macaca are highly susceptible to and die from experimental
or colony-acquired SIV infection, the virus has not been found
in natural populations of these species.
The mode of transmission of SIV among natural populations and
captive colonies of nonhuman primates has not been established.
Because SIV viruses are readily transmissible experimentally by
infected blood or serum, it is assumed that transmission occurs
via bite wounds contaminated by infected blood. Transplacental
transmission has been documented in a rhesus monkey with a naturally
acquired infection, but has not been proven in experimental infections.
SIV has been experimentally transmitted via the genital mucosal
route. It is likely that colony spread may occur through the reuse
of contaminated hypodermic needles.
Clinical Findings: Clinical signs and course of SIV
vary according to virus strain and the nature of opportunistic
infections. A maculopapular rash is often observed on the less
haired portions of the body during the first 6-8 weeks of infections
and it may persist for variable periods of time thereafter. Lymphadenopathy
of axillary and inguinal lymph nodes is common early in the course
of disease. It may persist until death in those animals that die
early, but usually subsides in animals with a more prolonged disease
course. The most consistent hematologic abnormality is a reduction
in the number of CD4+ lymphocytes in the peripheral blood and
measurement of absolute numbers of CD4+ lymphocytes is a useful
prognostic test. A progressive decline in the number of CD4+ lymphocytes
occurs just prior to the onset of clinical deterioration. The
clinical course of disease may be quite variable, even among animals
infected with the same virus strain.
Pathogenesis: SIV viruses have marked tropism for cells
expressing the CD4 molecule on their cell surface. The virus enters
cells through the interaction of the viral envelope protein, gp120
and the CD4 molecule which serves as the viral protein receptor.
Once inside the cell, the polymerase, reverse transcriptase, transcribes
viral RNA into DNA which is incorporated into the cellular genomic
DNA. Transcription of this proviral DNA results in progeny virus
which buds primarily from the surface of infected lymphocytes
and into cytoplasmic vacuoles in infected macrophages. In animals
in which the virus causes fatal disease, there is a profound drop
in the number of CD4+ lymphocytes resulting in severe immune dysfunction
and death from opportunistic infections or lymphoma.
- Etiology: The eight different SIV isolates from various
nonhuman primate species are classified in the subfamily Lentivirinae,
family Retroviridae. These isolates have variable homology with
the two human lentiviruses, HIV-1 and HIV-2, the etiologic agents
of human AIDS. The different SIV isolates are designated by a
three-letter subscripted suffix indicating the species from which
they were originally isolated. They include: SIVMAC from rhesus
monkeys (Macaca mulatta); SIVSMM from sooty mangabeys (Cercocebus
atys); SIVMNE from pig-tailed macaques (Macaca nemestrina); SIVSTM
from stump-tailed macaques (Macaca arctoides); SIVAGM from African
green monkeys (Cercopithecus aethiops); SIVMND from mandrills
(Mandrillus sphinx); SIVCMZ from chimpanzees (Pan troglodytes):
and SIVSYK from Sykes' monkeys (Cercopithecus mitis).
-
- Case 14-3a. Cerebrum. Shows a nest of multinucleated
cells in the deep cortex. 40X

- Case 14-3b. Cerebrum. Demonstrates variably sized
vacuoles in the neuropil. 20X
- AFIP Diagnosis: Brain, cerebrum: Meningoencephalitis,
histiocytic, perivascular, multifocal, mild, with multinucleated
giant histiocytic cells and diffuse moderate white matter spongiosis,
rhesus monkey (Macaca mulatta), primate.
Conference Note: Similarities between SIV-induced disease
in macaques and HIV-induced disease in humans make the macaque
an extremely important model for the study of AIDS. However, the
clinical course of the diseases differs in an important way. HIV-induced
disease in humans evolves over a period of years to decades following
infection, whereas SIV-infected rhesus monkeys usually die within
2 years postinfection. About one-third of infected animals develop
a very rapidly progressive disease leading to death within a few
months of virus inoculation. The remaining two-thirds develop
a more slowly progressive disease course leading to death in 1-2
years.5 In addition to lesions attributable to direct viral effects,
as described by the contributor, secondary infections commonly
contribute significantly to morbidity and mortality. These agents
include Pneumocystis carinii, Cryptosporidium spp., SV40, Mycobacterium
spp., cytomegalovirus, adenovirus, Giardia spp., Candida, Trichomonas,
and the recently described microsporidian Enterocytozoon bieneusi.
Contributor: FDA/CBER/DVS, HFM-270, Bldg. 29-A, Rm.
1A-17, 1401 Rockville Pike, Rockville, MD 20852-1448
References:
- 1. Narayan O, Joag SV, Stephens EB: Selected models of HIV-induced
neurological disease. Curr Top Microbiol Immunol 202:151-66,
1995.
- 2. Gardner MB, Dandekar S: Neurobiology of simian and feline
immunodeficiency virus infections. Curr Top Microbiol Immunol
202:135-50, 1995.
- 3. Lackner AA: Pathology of simian immunodeficiency virus
induced disease. Curr Top Microbiol Immunol 188:35-64, 1994.
- 4. King NW: Simian immunodeficiency virus infections. In:
Nonhuman
Primates I, Jones TC, Mohr U, Hunt RD, eds., pp. 5-20, Springer-Verlag,
1993.
- 5. Letvin NL, King NW: Immunologic and pathologic manifestations
of the infection of rhesus monkeys with simian immunodeficiency
virus of macaques. Journal of Acquired Immune Deficiency Syndromes
3(11):1023-1040, 1990.
- 6. King NW, Chalifoux LV, Ringler DJ, Wyand MS, Sehgal PK,
Daniel MD, Letvin NL, Desrosiers RC, Blake BJ, Hunt RD: Comparative
biology of natural and experimental SIVMAC infection in macaque
monkeys: a review. J Med Primatol 19:109-118, 1990.
Case IV - CHIEN RIEN (AFIP 2596251)
Signalment: Approximately 18-month-old, male, Beagle.
History: This dog was used in a chronic (1 year) toxicology
study. There were no clinical signs during the course of the study.
Gross Pathology: The right kidney was missing [agenesis].
The left kidney was enlarged, with pale yellowish cortex and sand-like
pinpoint discoloration in the cortex.
Laboratory Results:
Blood biochemistry: Creatinine (mg/dl): 5.52 (D7); 5.51 (D90);
6.66 (D181);
8.43 (D365)
BUN (mg/dl): 85 (D7); 93 (D90); 91 (D181); 99 (D365)
Urinalysis: Urinary volume (ml): 111 (D1); 160 (D86); 260 (D177);
900 (D363)
Density: 1.01 (D363)
Protein (mg/dl): traces (D1); traces (D86); 30 (D177); 30 (D363)
(D is for day of study)
Contributor's Diagnoses and Comments: Glomerular lipidosis,
segmental to diffuse, multifocal, marked; tubulo-interstitial
nephritis, chronic, multifocal, moderate.
- Changes observed in glomeruli (enlargement, dilation of glomerular
tufts and mesangial spaces by foamy cells presenting microvacuoles
and macrovacuoles) are consistent with glomerular lipidosis.
The pattern observed is segmental or total, and diffuse, since
almost all glomeruli exhibited minimal to marked Sudan black
positivity on frozen sections. On semi-thin sections, glomerular
tufts were enlarged, mesangial and pericapillary spaces being
filled with large foamy cells showing irregular nucleus, cytoplasmic
empty vacuoles, or large vacuoles with light blue content, and
dark granules in the cytoplasm. Ultrastructurally, enlarged cells
presented small to large empty vacuoles not membrane-bound, protein
droplets, filamentous material under the membrane, and irregular
outlines with projections into the mesangial matrix. Capillaries
appeared spared on semi-thin and EM examination. EM observations
made in this case are indicative of mesangial origin, which is
consistent with several literature reports, 1,2,6 although some
authors indicate endothelial origin. This lesion was associated
with slight increases in BUN and creatinine, that may be related
to the large extent of the lesion, while most cases reported
in the literature only show up to 20% of glomeruli affected,
without functional disturbances.2 Global incidence in beagle
dogs is about 4%.2 There is no mention in the literature of a
human counterpart to this lesion. This lesion differs from the
rare human "lipoprotein glomerulopathy" associated
with type III hyperlipoproteinemia and causing nephrotic syndrome,
in which capillaries are involved as well as mesangium.4,5
-

- Case 14-4. Kidney. Foamy lipid-containing mesangial
cells are expanding the glomerulus. The Bowman's capsule is moderately
thickened and fibrotic, forming synechia between the capsule
and the glomerular tuft. 20X
- AFIP Diagnosis: Kidney: Glomerular lipidosis, segmental
to global, diffuse, severe, with moderate periglomerular fibrosis
and chronic interstitial nephritis, Beagle, canine.
Conference Note: Conference participants agreed that
the extent of the glomerular lipidosis in this case is striking.
The clinical chemistry values indicate progressive loss of renal
function (markedly increased serum creatinine, mildly increased
blood urea nitrogen, proteinuria, and isosthenuria on Day 363).
These changes are not anticipated from uncomplicated glomerular
lipidosis. Further, glomerular lipidosis would not be expected
to cause the chronic inflammatory changes present in this kidney,
i.e. lymphoplasmacytic interstitial infiltrates and extensive
periglomerular fibrosis. These chronic changes are often seen
in mature dogs, and the etiology is usually unknown.
Upon recent communication with the contributor, it was noted
that this dog had been administered an intermediate dosage of
a neurotropic substance. This was the only dog in the study that
developed glomerular lipidosis. The changes were not considered
compound-related.
Contributor: Sanofi Research, 9 Great Valley Parkway,
P.O. Box 3026, Malvern, PA 19355.
References:
- 1. Thiel W, Hartig F, Frese K: Glomerular lipidosis in the
dog. Exp Path 19:154-160, 1981.
- 2. Zayed I, Gopinath C, Hornstra HW, Spit BJ, Heidjen CA:
A light and electron microscopical study of glomerular lipidosis
in beagle dogs. J Comp Path 86:509-517, 1978.
- 3. McCullagh K, Ehrhart LA: Non-arteriosclerotic lesions
in the kidney of dogs fed an atherogenic diet. Exp & Mol
Pathol 22:400-416, 1975.
- 4. Zhang P, Matalon R, Kaplan L, Kumar A, Gallo G: Lipoprotein
glomerulopathy: first report in a Chinese male. Am Journ of Kidney
Diseases 24(6):942-950, 1994.
- 5. Meyrier A, Dairou F, Callard P, Mougenot BL Lipoprotein
glomerulopathy; first case in a white European. Nephrol Dial
Transplant 10:546-549, 1995.
- 6. Maxie MG: The urinary system. IN: Pathology of Domestic
Animals, 4th ed., vol. 2, pp. 486-7, Academic Press, San Diego,
1993.
Terrell W. Blanchard
Major, VC, USA
Registry of Veterinary Pathology*
Department of Veterinary Pathology
Armed Forces Institute of Pathology
(202)782-2615; DSN: 662-2615
Internet: blanchard@email.afip.osd.mil
* The American Veterinary Medical Association and the American
College of Veterinary Pathologists are co-sponsors of the Registry
of Veterinary Pathology. The C.L. Davis Foundation also provides
substantial support for the Registry.
Return to WSC Case Menu.